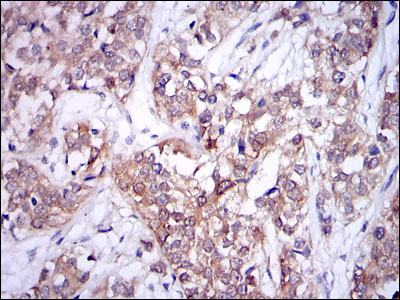
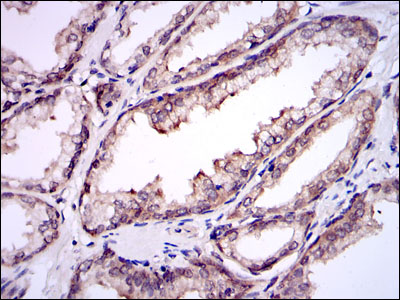

-
Product Name
Anti-Ubc9/UBE21 (1D6) Mouse antibody
- Documents
-
Description
Ubc9/UBE21 (1D6) Mouse monoclonal antibody
-
Tested applications
WB, IHC-P, ICC/IF, FC
-
Species reactivity
Human, Monkey
-
Isotype
Mouse IgG1
-
Preparation
Antigen: Purified recombinant fragment of human UBE2I expressed in E. Coli.
-
Clonality
Monoclonal
-
Formulation
Ascitic fluid containing 0.03% sodium azide.
-
Storage instructions
Store at 4°C short term. Store at -20°C long term. Avoid freeze / thaw cycle.
-
Applications
WB: 1/500 - 1/2000
IHC: 1/200 - 1/1000
ICC: 1/200 - 1/1000
FC: 1/200 - 1/400
ELISA: 1/10000
-
Validations

Flow cytometric analysis of HepG2 cells using UBE2I mouse mAb (green) and negative control (red).
Immunohistochemical analysis of paraffin-embedded bladder cancer tissues using UBE2I mouse mAb with DAB staining.

Western blot detection of Ubc9 in C6,Jurkat,K562,3T3 and Hela cell lysates using Ubc9 mouse mAb (1:2000 diluted).Predicted band size:18KDa.Observed band size:17KDa.

Immunofluorescence analysis of HepG2 cells using UBE2I mouse mAb (green). Blue: DRAQ5 fluorescent DNA dye. Red: Actin filaments have been labeled with Alexa Fluor-555 phalloidin.

Western blot analysis using UBE2I mouse mAb against Hela (1), HepG2 (2), and Cos7 (3) cell lysate.
Immunohistochemical analysis of paraffin-embedded prostate tissues using UBE2I mouse mAb with DAB staining.
-
Background
Swiss-Prot Acc.P63279.The modification of proteins with ubiquitin is an important cellular mechanism for targeting abnormal or short-lived proteins for degradation. Ubiquitination involves at least three classes of enzymes: ubiquitin-activating enzymes, or E1s, ubiquitin-conjugating enzymes, or E2s, and ubiquitin-protein ligases, or E3s. This gene encodes a member of the E2 ubiquitin-conjugating enzyme family. Four alternatively spliced transcript variants encoding the same protein have been found for this gene.
Related Products / Services
Please note: All products are "FOR RESEARCH USE ONLY AND ARE NOT INTENDED FOR DIAGNOSTIC OR THERAPEUTIC USE"
